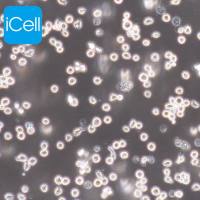
HL60 人早幼粒白血病细胞|HL60细胞|HL-60|HL-60细胞|STR鉴定|镜像绮点(Cellverse)

相关产品推荐更多 >
万千商家帮你免费找货
0 人在求购买到急需产品
- 详细信息
- 询价记录
- 文献和实验
- 技术资料
- 英文名:
HELA-luc
- 库存:
100
- 供应商:
镜像绮点
- 肿瘤类型:
宫颈癌
- 细胞类型:
细胞系
- ATCC Number:
-
- 品系:
细胞系
- 组织来源:
宫颈
- 相关疾病:
宫颈癌
- 物种来源:
组织
- 免疫类型:
否
- 细胞形态:
上皮细胞样
- 是否是肿瘤细胞:
-
- 器官来源:
宫颈
- 运输方式:
冻存/复苏
- 年限:
长期
- 生长状态:
贴壁培养
- 规格:
T25
细胞介绍
角蛋白免疫过氧化物酶染色阳性。 有报告称MS751细胞含有人乳头状瘤病毒18 (HPV-18)序列。据报道,p53表达水平低,pRB(成视网膜细胞瘤抑制因子)表达水平正常。
该细胞通过慢病毒转染的方式携带Luc基因。
细胞特性
1) 来源:宫颈腺癌
2) 形态:上皮细胞样,贴壁生长
3) 含量:>1x106 个/mL
4) 污染:支原体、细菌、酵母和真菌检测为阴性
5) 规格:T25瓶或者1mL冻存管包装
细胞筛选
该细胞为稳定转染Luc的细胞,随细胞传代次数的增加,其Luc荧光强度会逐渐减弱。若实验要求需要维持荧光强度,可以加入嘌呤霉素进行再次筛选。
建议收到细胞后至少传3代,冻存留种后再进行筛选。
初次进行细胞筛选时,建议加入终浓度为1ug/ml嘌呤霉素的完全培养基维持培养,若无细胞漂浮或者漂浮较少,即可更换为含2ug/ml嘌呤霉素的完全培养基继续筛选,以此类推,至最高药物浓度为5ug/ml。若筛选过程中,漂浮细胞大于60%,则停止筛选,换成正常培养基培养,至细胞密度约80%,可继续加入同浓度嘌呤霉素进行筛选。当加入5ug/ml嘌呤霉素时细胞正常增殖,可停止筛选,用不含药完全培养基正常培养。
细胞培养步骤
一.培养基及培养冻存条件准备:
1) 准备MEM(推荐iCell-0012)培养基;优质胎牛血清,10%;双抗1%。
2) 培养条件: 气相:空气,95%;二氧化碳,5%。 温度:37摄氏度,培养箱湿度为70%-80%。
3) 冻存液:90%血清,10%DMSO,现用现配。
二. 细胞处理:
1) 复苏细胞:将含有1mL细胞悬液的冻存管在37℃水浴中迅速摇晃解冻,加入4mL培养基混合均匀。在1000RPM条件下离心4分钟,弃去上清液,补加1-2mL培养基后吹匀。然后将所有细胞悬液加入培养瓶中培养过夜(或将细胞悬液加入250px皿中,加入约8ml培养基,培养过夜)。第二天换液并检查细胞密度。
2) 细胞传代:如果细胞密度达80%-90%,即可进行传代培养。
业务范围



风险提示:丁香通仅作为第三方平台,为商家信息发布提供平台空间。用户咨询产品时请注意保护个人信息及财产安全,合理判断,谨慎选购商品,商家和用户对交易行为负责。对于医疗器械类产品,请先查证核实企业经营资质和医疗器械产品注册证情况。
- 作者
- 内容
- 询问日期
 文献和实验
文献和实验在生物学与医学研究中,HeLa细胞是指源自一名美国妇女的子宫颈癌细胞的细胞。这名美国妇女名叫Henrietta Lacks,于1951年死於癌症。本来为了让Lacks保持匿名,此细胞株宣称是依"Helen Lane"命名。HeLa细胞株被George Gey分送给众研究单位(而未通知Lacks本人也未得到她的许可),因用作癌症研究而广为流传。至今已被视为“不死的”,也就是说此细胞株(不同于其他人类细胞)不会老死,而且可以不限次数的分裂下去,而且已被培养出一个不间断的系列。此细胞株即使和其他癌细胞
HeLa is one of the oldest and most commonly used cell lines in biomedical research. Owing to the ease of which they can be effectively synchronized by various methods, HeLa cells have been used extensively for studies of the cell cycle
Preparation of HeLa Nuclear Extracts
Promoter-specific in vitro transcription by RNA polymerase II is now achievable with cell extracts prepared from a variety of animal and plant sources (1 –3 ). For extracts prepared from mammalian cells, HeLa cells provide many advantages
 技术资料
技术资料